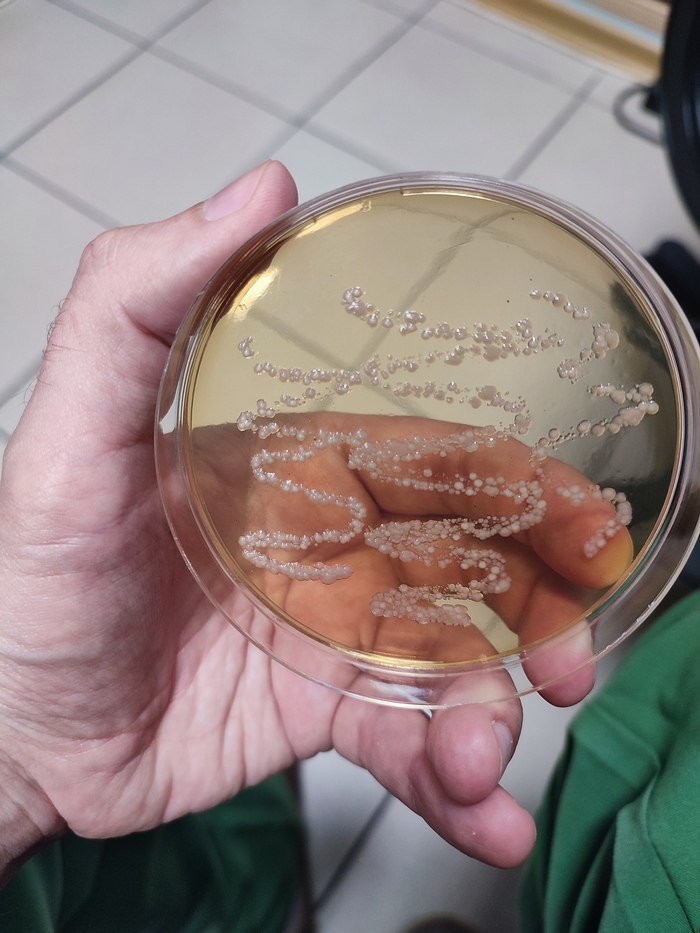
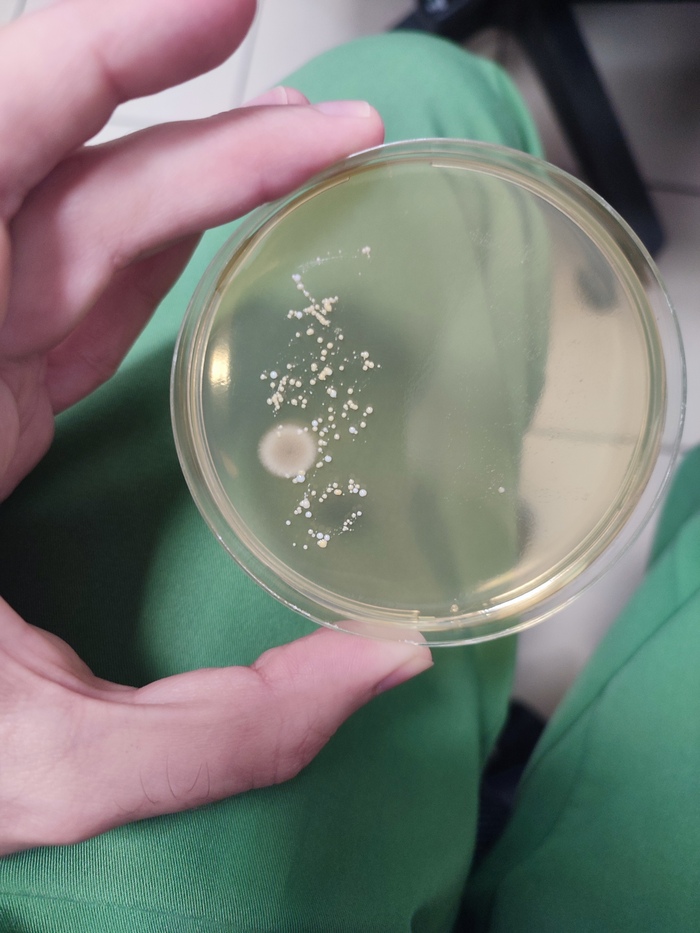
Мазок из носа

Лига Микробиологов
Органайзер работает хорошо)
Если мне не надо вставать на работу, я не буду слышать будильник, или реагировать на него. Буду спать как мертвец. 10 дней пролежал, в телефоне стоят 4 будильника и я их не менял, не сдвигал время. Все 10 дней я их вообще не слышал. Сегодня был страх, что я не услышу будильник и не проснусь вовремя. Лег спать с намерением, что надо вставать на работу. Проснулся раньше будильника на 10 минут. Хороший у меня органайзер внутри).
Деление клетки, наглядно
Без микроскопов и макросъёмки
Кто живет в йогурте
Купил я хлебопечку, в которой можно делать йогурт. Сначала выпек хлеб. Затем решил сделать йогурт. Залил молоко, добавил ложку магазинного йогурта и через 8 часов что-то получилось.
Йогурт перелил в банку, стал отмывать хлебопечку и неожиданно обнаружил, что перед приготовлением йогурта плохо отмыл хлебопечку. Просто не сообразил, что нужно снять перемешивающий винт и отмыть застрявшее под ним тесто.
Появилось у меня сомнение, а йогурт ли получился или это дрожжи из теста сквасили молоко. На вкус вроде он, но от магазинного отличается, так что непонятно.
Решил я изучить полученный продукт под микроскопом. Тем более, что микроскоп у меня был наготове. (Я им себе анализ крови делаю, о чём писал в предыдущем посте.) Нашёлся у меня и краситель (methylene blue), который помогает рассмотреть бактерии и дрожжи.
Я не специалист в микробиологии, потому для сравнения развёл и покрасил дрожжи, надеясь, что смогу их сравнить с тем, что выросло в молоке и понять, то ли у меня выросло.
Оказалось всё гораздо проще, чем я думал. Размеры дрожжей намного больше размера бактерий в йогурте, так что перепутать их невозможно.
Вот такие фотографии у меня получились. Оба снимка в одном масштабе: слева дрожжи, справа йогурт. На снимке йогурта бактерии в середине, а по краям свернувшееся молоко.
К стати, кто-то знает, почему одни клетки дрожжей оказались окрашенные, другие нет? Окрашенные - это погибшие?
Еще одним открытием для меня стало то, что бактерии в йогурте шевелятся. Вот видео моего йогурта:
А это магазинный:
В магазинном йогурте мне показалось, что микробы более разнообразные. Думаю там выросло что-то лишнее, пока он стоял открытым в холодильнике.
Дальше я решил распознать бактерии.
Изучив состав йогурта, написанный на банке внимательнее я обнаружил, что кроме йогуртовых культур в составе есть пробиотики:
На этикетке отдельными пунктами выделены живые йогуртовые культуры (LIVE YOGURT CULTURES) и живые культуры пробиотиков (LIVE PROBIOTIC CULTURES), которые видимо добавлены в уже готовый йогурт.
Я думаю, что при приготовлении йогурта пробиотики при 40 градусах плохо растут или даже гибнут и остаются только йогуртовые культуры. Так что в моем йогурте пробиотиков нет.
На мой непрофессиональный взгляд вот эта парочка бактерий и есть производители йогурта: Streptococcus thermophilus (слева) и Lactobacillus bulgaricus (справа).
Кроме этого видно множество мелких, быстро двигающихся бактерий, но вот опознать их я уже не смог. Вот три примера таких бактерий. Фотографии снизу - это та же бактерия, что и сверху только в следующий момент времени.
Буду рад, если кто-то сможет сказать, что это такое.
И еще вопрос к специалистам. Правильно ли я понял, что отличить под микроскопом пробиотики, указанные на банке от йогуртовых культур сложно или даже невозможно?
Учет дезсредств
Подскажите пожалуйста!
Учет, концентрация, сроки годности дезинфицирующих растворов ведется только в письменном носителе или можно в электронном? Могу ли я часть заполнять в электроном варианте, например те растворы которые повторяются каждый день(для чистой и грязной зон,для дез ковриков, для замачивания пипеток и т.д.),а те растворы, которые меняется раз в неделю или по необходимости наводятся, их записывать в бумажный журнал?